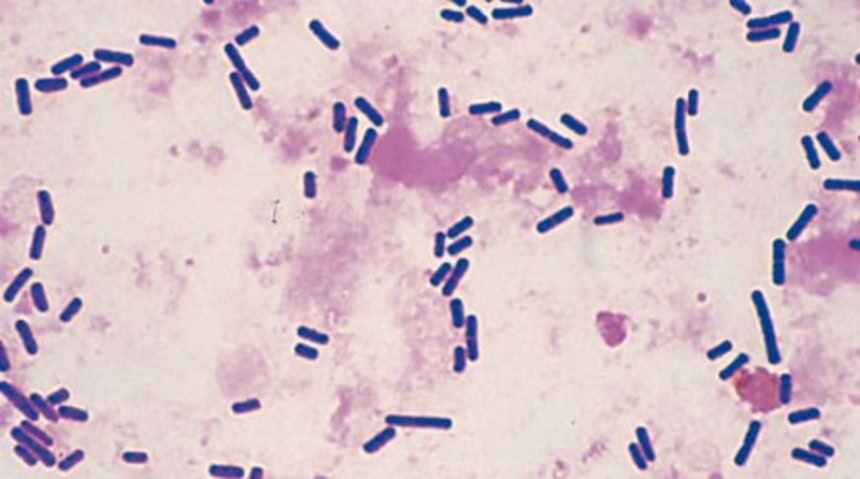
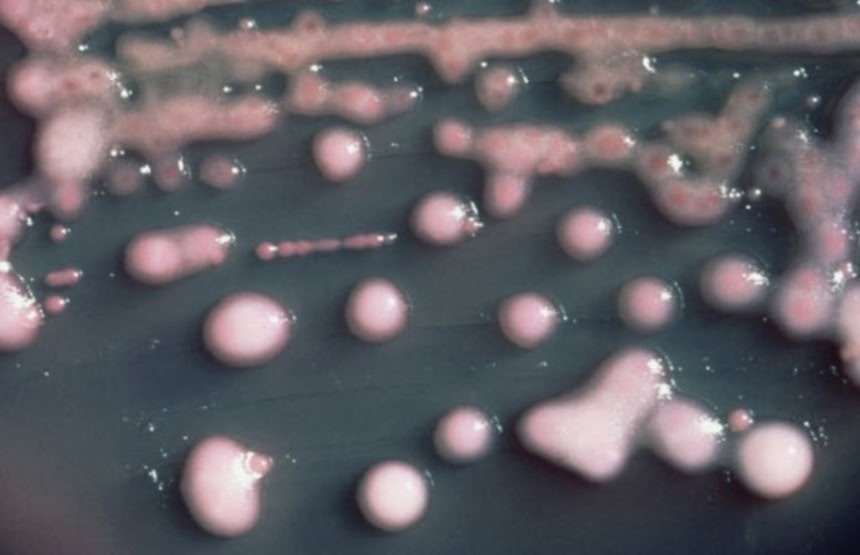

この画像を大きなサイズで見る
この画像を大きなサイズで見る食中毒、発熱、肺炎などを引き起こす微生物はそこかしこに潜んでいる。こうした一般的な細菌は、通常人体の様々な部位に人知れず存在しており、ある日我々に牙を剥き、人体を蝕みはじめるのだ。 周辺組織を破壊し、肉体を壊死させ、脳を喰らう、そんな恐ろしい10種の病原菌とそれにより引き起こされる病気を見ていこう。
10. 化膿レンサ球菌
 この画像を大きなサイズで見る
この画像を大きなサイズで見るA群レンサ球菌とも呼ばれ、通常は皮膚などに潜む常在菌であるが、元来から病原性があるため、連鎖球菌性咽頭炎や猩紅熱を引き起こすことがある。症状が重篤な場合は、壊疽性筋膜炎を引き起こす。アメリカ疾病予防管理センター(CDC)の報告によれば、1999年には600件の壊疽性筋膜炎が発生している。また毒素や酵素を放出し、周辺組織を直接攻撃することもある。
治療を行わない場合、広範囲が冒され、死に至る。現在懸念されるのは、新たに発見されたemm89という病原性の強い新株が広まりつつあることだ。なお、こうした症状が出るのは、一般に糖尿病などで免疫が低下している場合であることに注意してほしい。
9. アポフィソマイセス
 この画像を大きなサイズで見る
この画像を大きなサイズで見る土の中には無数の微生物が存在する。アポフィソマイセスもそうした真菌の1つだ。滅多にないことではあるが、感染してしまえばムコール菌症を引き起こす。ムコール菌症はアポフィソマイセスだけではなく、クモノスカビやリゾムコールなど、様々な真菌によって生じる症状だ。
2011年にアメリカ、ミズーリ州ジョプリンを台風が襲ったとき、この病気による不幸な事例があった。台風によって怪我をした13名が真菌に感染してしまい、菌糸によって周辺の組織が冒され始めたのだ。血管が損傷し、血流も滞ると、組織が壊死し始める。専門家によれば、台風によって土壌内部の真菌が傷口に付着し、感染してしまったようだ。
8. リーシュマニア
 この画像を大きなサイズで見る
この画像を大きなサイズで見るある状況では、ハエに刺されることで壊疽性の病気にかかる可能性もある。リーシュマニアは、ヨーロッパ南部を含む、熱帯や亜熱帯で一般的なサシチョウバエ類によって媒介される原虫である。これを媒介するハエに刺されることで感染し、体内で成長したものが周囲の細胞を冒し始める。感染した細胞は、原虫の住処となり、やがて膨れ上がり壊死する。
壊死や腫れが起きるのはほとんどの場合、刺された部位の周辺であるが、ごく稀に原虫が別の部位にも移動して症状を引き起こすこともある。
リーシュマニア症には、皮膚リーシュマニア症と内臓リーシュマニア症の2種類がある。前者は皮膚を冒し、後者は内臓を冒す。現在、戦乱の続くシリアでリーシュマニア症が流行しており、またアマゾンやアフリカへの旅行者も注意が必要である。
7. エロモナス・ハイドロフィラ
 この画像を大きなサイズで見る
この画像を大きなサイズで見る河口など、淡水域に潜む。機能の低下したものや即席の浄水器などのせいで、飲料水が汚染されることもある。また汚染水で食品や調理器具を洗い、食品が汚染されることもある。低温に耐性があるために、冷蔵で汚染を防ぐことはできない。旅行者がよく感染して下痢を起こすため、渡航者下痢症とも呼ばれる。
稀ではあるが、傷口に汚染水が触れることで感染し、壊死を引き起こす。2012年にジョージア州で、ジップラインというロープと滑車付きの遊具による事故で怪我をした女性が、エロモナス・ハイドロフィラに感染してしまった。一般的な治療法は、感染部位の切断や切除である。傷がある場合は、水の中に入らないよう注意するに越したことはない。
6. バクテロイデス・フラジリス
 この画像を大きなサイズで見る
この画像を大きなサイズで見る人間の腸内、特に結腸など、酸欠環境で繁殖する。体内に大量に存在する常在菌であり、消化を助け、他の病原菌の侵入を防ぐ役割を果たしている。腸内の環境に非常によく適応しているため、大抵は他の外部の細菌よりは強い。
皮肉なことに、通常なら有益なはずのこの細菌が手術や外傷を負うような怪我で体外へと出た場合、大量の膿と浮腫を特徴とする重篤な壊死を起こしてしまう。抗生物質を分解する酵素を産生し、ペニシリンやその近類を破壊するために、治療は厄介である。通常はカルバペネム系抗生物質を使用するが、その濫用は耐性菌を生み出す危険がある。
5. ウェルシュ菌
この画像を大きなサイズで見る
この画像を大きなサイズで見るボツリヌス中毒を起こすボツリヌス菌の近類である、クロストリジウム属に属する嫌気性桿菌。土壌のほか、人間の腸内の常在菌であるが、ビフィズス菌と比較される悪玉菌の代表で、臭いオナラの臭いと関係する。また生肉や卵に多く潜み、こうした食材を未調理で食べたときの食中毒の原因でもある。重篤なケースでは、化膿連鎖球菌、アエロモナス細菌、バクテロイデス・フラジリスのような壊死を引き起こす。
皮膚表面や筋肉の深部を冒すため、治療のために切断が必要になることがある。またガス壊疽という体組織の腐敗を特徴とする合併症も生じさせる。汚染された土壌に傷口が触れることで感染することが多い。傷口が汚れやすい戦場などでよく見られる症状だ。
4. クレブシエラ・ニューモニエ
この画像を大きなサイズで見る
この画像を大きなサイズで見る口腔や腸内における常在菌である。非常に強い耐抗生物質性を示し、肺炎、血流感染、髄膜炎など、様々な病気と関連している。病院内のカテーテルや呼吸器から感染することが多い。
稀ではあるが、壊死を起こすこともある。北アメリカで初めて記録に残されたのは、カリフォルア州に住んでいたフィリピン人女性で、クレブシエラ・ニューモニエに感染して筋壊死を起こしていた。その論文によれば、クレブシエラ・ニューモニエが広く存在する南アジアでよく見られる症状だったという。
抗生物質が効き難いため治療は難しく、ペニシリンはおろか、新世代の薬剤に対しても耐性を身に付けつつある。
3. ビブリオ・バルニフィカス
 この画像を大きなサイズで見る
この画像を大きなサイズで見るコレラの原因であるコレラ菌と同じ属に属す。増殖に塩水を必要とするため汽水域の海水に棲息し、カニなど、海産物を感染源とする。症状は下痢や嘔吐などであるが、免疫低下状態にある場合は肝疾患を引き起こす場合もある。
また傷口が海水に暴露し感染した場合は、壊死を引き起こす。沿岸部では一般的な感染症で、フロリダではこの症状により毎年9人が亡くなっている。ビブリオ・バルニフィカスによる壊死を防ぐには、傷があるときは海に近づかないことであるが、菌が繁殖しやすい暖かい季節には特に注意を要する。日本では”人喰いバクテリア”として知られる。
2. 黄色ブドウ球菌
 この画像を大きなサイズで見る
この画像を大きなサイズで見る人間や動物の皮膚や消化管に存在する常在菌である。CDCによれば、世界人口の30%が鼻腔付近に黄色ブドウ球菌を有しているが、多くの場合は症状を引き起こすことはない。怪我や手術時における血流感染や心内膜炎と関連する。摂食した場合、黄色ブドウ球菌が放出する毒素によって食中毒を起こす場合がある。調理によって殺菌できるが、毒素自体を破壊されずに残る。
極端な事例では、壊死を起こすこともある。一般的なのは、糖尿病や高血圧などの患者においてであり、免疫が低下した状態にあれば容易に体内に侵入し、人体組織を破壊する。多くの場合、様々な抗生物質に耐性を示すメチシリン耐性黄色ブドウ球菌(MRSA)に起因するため、この感染症の治療は困難である。
1. フォーラーネグレリア
 この画像を大きなサイズで見る
この画像を大きなサイズで見るこれを知った後は水の中に入れなくなるかもしれない。湖や川などの淡水に存在するアメーバで、”殺人アメーバ”の異名に相応しく脳を喰らう。鼻腔内に侵入すると、嗅神経から脳に侵入し、これを冒す。フォーラーネグレリアが通常餌とするのは細菌などであるが、脳内にはそれが乏しいため、代わりに脳に手をつけるわけだ。
自然環境の水域が一般的な感染源であるが、汚染されたプールや水道水から感染することもある。留意すべきは、鼻腔内を通過しない限りは、汚染水によって感染しないことだ。アメーバが口や他の開口部から入った場合に感染することはない。
フォーラーネグレリアによる原発性アメーバ性髄膜脳炎は稀ではあるが、発症すれば大抵は死に至る。現時点では、これに有効な薬剤が存在せず、最後の手段として外科手術に頼るよりない。予防には、未処理の淡水を避けることである。塩素で処理されたプールや水道なら普通は安全なはずだ。
via:listverse・written hiroching
















「かもすぞー(野太い声)」
世の中悪質細菌だらけだ
どこにいても逃げきれんし、なんでこいつらって
何を楽しみにして悪さするのだ
※2
菌は悪さをしてるんじゃなくて食べもの食べて出すもの出してるだけ
実は食物連鎖の頂点は彼等です。
ウマウマうー
たまたま生態が人間と相性悪かっただけで別に好き好んで悪さをしてるわけではないけど
菌にも個性とか意思とかあるの??
人類が出現するずっと前から活動してる細菌からしたら、後発の人類ごときに
お前ら最悪だから言われても困るだろな。
人間がゾンビになるウイルスや細菌って、実在するんだろうか?
微小な生物ほど、共生する術を持っているね。
地球の優秀な清掃係りだし。
他を際限なく排除しようとするのは人類だけの
ようなきがする。
※9
ねーよ!と切って捨てる方も多いかと思いますが、それは性急に過ぎます。
ニューロンネットワークがどうとか色々頑張って調べ中ですが、実は「意識」というモノが何なのか、現時点でははっきりしていないのです。
「昆虫以下にはねーよ!」という方もいらっしゃれば「いや人間が意識と考えてるモノだって幻かも…」「いやこの成長する結晶にもひょっとして意識が…」という方も居ます。
脳に一極集中しているかもしれないし、脳は単なる意識流通センターで、体の細胞のひとつひとつに微弱な意識があるかもしれません。
だとすると、菌にも意識がないとは言いきれないのです。
(私達の考える「意識」と同じものかは別として…)
腸内細菌が変わると
食べ物の好みも変わるなんて聞くし
案外人間なんてこいつらのために生きてんのかもよ
口腔の常在菌にもやばいのが居るのか
ネグレリア フォーレリあったね
画像見たらマジでトラウマになった
某番組のトラウマ回がA群レンサ球菌。
小学生の時息をするのが怖かったでござる。
今日の歯医者で細菌検査やってきた俺には怖すぎる記事だ
菌ってあんなウヨウヨ動いてるんだな…
生物みな寄生虫、地球に住み着いている寄生獣
感染学やるとこの辺みんな聞くねぇ…
壊死ではないのもあるけど
アフリカ睡眠病を引き起こすトリパノソーマとか
政治家に送りつけるので流行った炭疽菌による皮膚炭疽とか
クロストリジウム属によるガス壊疽とか
いろいろドギツイのかましてくれるのが感染症だよね
風邪で病院行くと抗生物質もらうけど、ほとんどの原因はウイルス感染だから抗生物質は無効。それでも「抗生物質出してくれたから安心」っていう気持ちに応えるためにどこでもクラ○ットとか出してる。こういう安易なのが耐性菌増やしてる一因。
リーシュマニア症の患者さんの写真は「目黒寄生虫館」で見たっけなぁ、今突然思い出した
※20
「意識」ではなく「意思」と書かれてましたね。申し訳ありません。
ここで言う「意識」は広義のものとして「意思」を含むので、読み替えてしまってください。
とはいえ滔々と語ってしまいなんか恥ずかしいです…。
もやしもん(inferno)
アメリカだったか「鼻うがい」した際にアメーバが体内に侵入ってニュース無かったっけ?
日本の水道水ならどこでも塩素消毒されてるから問題ないと思うが
ハンセン病も迷惑な病気だったな。こんな病気がなければいいのに・・・
軽い塩素位で死なないから鼻うがい容器や屋上タンクで汚染された水や水遊施設の水や温浴施設の水が鼻から入るとアメーバ感染する原因になるのだが